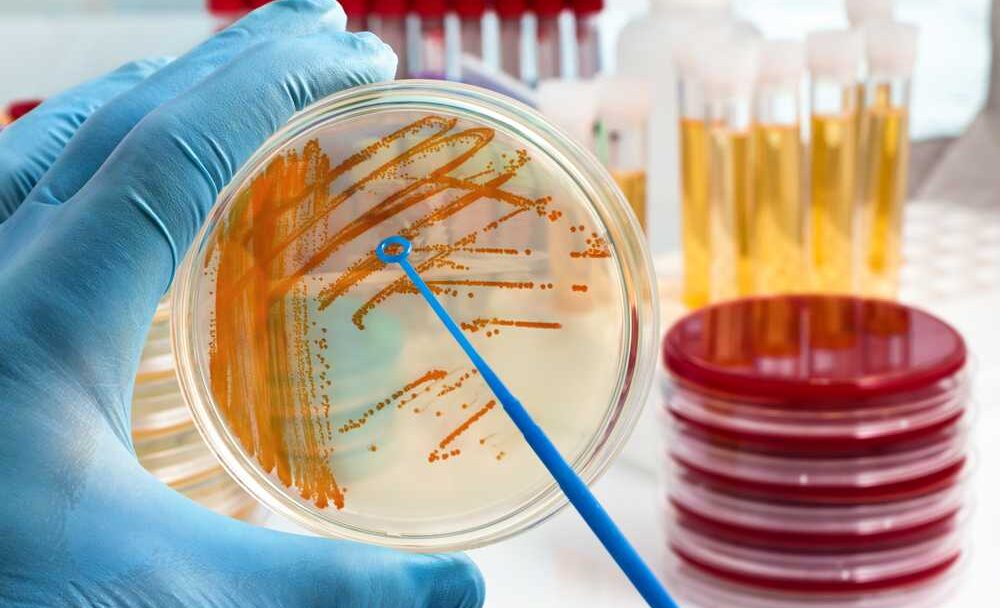

Streptokok agalactiae. Jaké nebezpečí představuje pro novorozence?

Redakce
16. 2. 2018
Přibližně každá čtvrtá žena má v pochvě přítomného streptokoka. Ačkoli nemusíte mít žádné negativní příznaky, je potřeba situaci nepodceňovat a důsledně hlídat, zejména v souvislosti s porodem. Pokud by vám nebyla podána antibiotika během porodu, mohlo by miminko díky streptococcus agalactiae v porodních cestách onemocnět zápalem plic, což je pro novorozence vážná komplikace.
Streptokok v pochvě
Streptokoky představují druh bakterií, který má různé kmeny. Některé kmeny patří mezi normální obyvatele tělních povrchů a onemocnění způsobují pouze za určitých okolností. Jiné ovšem mohou představovat značné riziko. Typickým zástupcem druhé skupiny těchto bakterií je Streptoccocus pyogenes (patří mezi skupinu A) a který způsobuje angínu. Porodníky zajímá především bakterie rodu Streptoccus agalactiae
Streptococcus agalactiae
Streptococcus agalactiae patří mezi normální obyvatele trávicího traktu mužů a žen. V řadě případů se vyskytuje v pochvě ženy, aniž je jeho přítomnost provázena výtokem či jinými problémy. V takových případech není potřeba přítomnost bakterie nijak řešit. Pokud se ovšem objeví výtok nebo když žena plánuje otěhotnění, je potřeba streptokoka v pochvě začít léčit. Zpravidla je výtok zaléčen po návštěvě gynekologa různými léky. Při výskytu obtěžujícího výtoku se těhotným ženám podávají zaváděcí vaginální čípky slučitelné s těhotenstvím (např. Macmiror, Framykoin, Polygynax atd.).
Čtěte také: Péče o zuby v těhotenství. Jak má vypadat a proč se zuby více kazí?
Streptokok v pochvě – komplikace
Výskyt streptokoka v porodních cestách dosud netěhotných žen může být příčinou infertility. Někdy stojí za častými potraty. Gynekolog proto provádí pravidelný stěr z pochvy, který přítomnost streptokoka v pochvě vyvrátí či potvrdí. Doporučuje se odebrat na kultivaci také moč. Někdy se totiž ukrývá i zde a je potřeba přeléčit přítomnost bakterie v moči. Jediná bakterie, jejíž výskyt v porodních cestách je spojen se závažnými novorozeneckými infekčními komplikacemi, je streptococcus agalactiae. Ostatní bakterie nemají ve vztahu k ohrožení plodu žádný význam, obávat se jich nemusíme.
Lze se streptokoka agalactiae v pochvě zbavit?
Bohužel je však tato bakterie z porodních cest prakticky nevymýtitelná. Mnohdy totiž vycestuje z konečníku do pochvy opět již krátce po přeléčení. Informace o výskytu streptokoka je pro nás ale velmi důležitá. Bez ohledu na to, jak dopadnou další stěry v těhotenství, musí být již těhotná žena vedena jako streptokok-pozitivní. Tuto informaci má také výrazně vyznačenu na těhotenské průkazce. Každá žena by měla mít na konci těhotenství proveden stěr z porodních cest, jehož cílem je pátrat cíleně po této bakterii.
Co to znamená pro novorozence?
Streptococcus agalactiae patří mezi streptokoky skupiny B (nebo také také GBS – z anglického Group B Streptococcus). Tyto bakterie mohou způsobit u novorozence poměrně závažnou infekci (zápal plic, zánět mozkových blan atd.). Naštěstí lze těmto závažným komplikacím účinně předcházet podáním antibiotik matkám v průběhu porodu.
Jak častý je streptokok v pochvě?
Streptococcus agalactiae se v porodních cestách českých žen vyskytuje v přibližně 20%. Streptokok patří mezi přirozené obyvatele trávicího ústrojí mužů a žen, není ale přítomen u všech lidí. Tato bakterie vycestuje u určitého procenta žen (především na konci těhotenství) z trávicího ústrojí do porodních cest. V naprosté většině případů jen „obývá“ porodní cesty.
Čtěte také: Koupání během těhotenství. Je bezpečná vana či bazén a jak se chránit?
Co s tím?
Bylo zjištěno, že jakékoliv snahy o definitivní vymýcení bakterií z porodních cest jsou neúspěšné. Bakterie osídlí pochvu znovu již za několik dní po dobrání antibiotik. Pouhé podání vaginálních čípků těhotným ženám tedy rozhodně nestačí. Je proto nutné podat antibiotika k porodu a to ve formě nitrožilní infuze. Tento způsob podání antibiotik totiž zajistí dostatečnou ochranu plodu před výskytem časných novorozeneckých infekčních komplikací. Antibiotika k porodu dostane tak jako tak každá rodička také tehdy, když odtéká plodová voda více jak 12 hodin. Může totiž dojít k postupu bakterií z konečníku do porodních cest (stěry z konečníku nejsou běžné – ačkoli tedy nebyl streptokok prokázán v pochvě, není vyloučené, že je v konečníku). Při porušení obalů plodu mohou bakterie postupovat přímo k plodu.
Pozor na domácí porody!
Díky prováděné profylaxi (ochrannému podávání antibiotik) se naštěstí podařilo novorozenecké streptokokové infekce prakticky vymýtit. Ochrana novorozence před streptokokovou infekcí je také jedním z důvodů, proč jsou velice riskantní domácí porody.